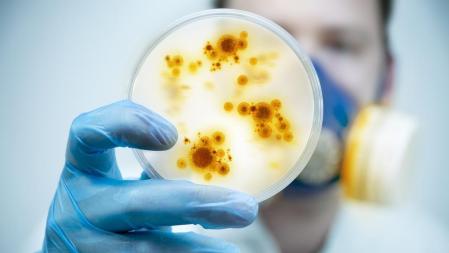
Horizontal

Hace unos meses, un documental se sitúo como la película más vista de la plataforma Netflix. La sorpresa es que, con el revelador título de Descifra tu salud: Los secretos del intestino, estaba dedicado a la salud intestinal. Su éxito dice mucho del arrollador interés por la microbiota que se ha generado entre la población.
Sari Arponen, doctora en Ciencias Biomédicas, internista, docente e investigadora especializada en cómo la microbiota influye en nuestra salud a cualquier edad, señala que su importancia es especialmente significativa en la madurez. “Puede ayudar a retardar el envejecimiento, al mejorar la función del sistema inmunitario, al ayudar al cuerpo a defenderse mejor contra infecciones y enfermedades”, señala la autora de libros como ¡Es la microbiota, idiota! O En la cocina con Sari Arponen. Además, recuerda que hay modos de mejorarla. Por ejemplo, “una alimentación prebiótica y antiinflamatoria es fundamental para la salud intestinal y el envejecimiento saludable”.
Hablamos con ella de cómo lograr el equilibrio microbiano para, entre otras cosas, mejorar la resistencia a la insulina y disminuir el riesgo de enfermedades cardiovasculares. La doctora Arponen revela las claves que ayudan a asegurar una buena salud intestinal.
¿Cuál es la relación entre la microbiota y el proceso de envejecimiento?
La microbiota es el conjunto de microorganismos que tenemos en el cuerpo, está formada por bacterias, hongos, arqueas, virus y protozoos. La hay en la boca, la piel, el tracto urogenital, el aparato respiratorio y, por supuesto, en el intestino. La microbiota intestinal es la más investigada y conocida y desempeña un papel crucial en la salud; también en el envejecimiento. A medida que cumplimos años, su composición y su diversidad tienden a cambiar, lo que puede influir en el proceso de envejecimiento de varias maneras.
¿De qué maneras? ¿Cómo puede influir una microbiota saludable en el proceso de envejecimiento?
Puede ayudar a retardar el envejecimiento, al mejorar la función del sistema inmunitario, al ayudar al cuerpo a defenderse mejor contra infecciones y enfermedades. Además, coopera para regular la inflamación crónica de bajo grado, un proceso que sucede en el envejecimiento y que está asociado a diversas enfermedades crónicas. Una microbiota saludable puede prevenir esa inflamación, ya que cumple una función metabólica, porque modula el funcionamiento de procesos claves como la regulación del metabolismo energético. Y protege la salud cerebral porque existe una conexión bidireccional entre el intestino y el cerebro, el eje intestino-cerebro. Así, una microbiota equilibrada puede influir positivamente en el estado de ánimo y la función cognitiva. Y por último destacaría que facilita la digestión y promueve la absorción de nutrientes esenciales, fundamentales para la salud general.
La microbiota coopera para regular la inflamación crónica de bajo grado, un proceso que sucede en el envejecimiento y que está asociado a diversas enfermedades crónicas
¿Qué impacto tiene la salud intestinal en la calidad de vida de las personas mayores?
La salud intestinal impacta directamente en la calidad de vida de las personas mayores. Problemas gastrointestinales, como la hipoclorhidria [la falta de ácido en el estómago] o las alteraciones del tránsito intestinal, son más comunes en la senectud, y pueden afectar significativamente la calidad de vida. Mantener una microbiota equilibrada puede mejorar la función digestiva, reducir los síntomas gastrointestinales y contribuir a un bienestar general.
¿Qué papel juega la microbiota en los cuidados para un envejecimiento saludable?
Todo lo que hacemos influye en el estado de nuestra microbiota y de nuestras propias células. Por ello es clave conocer sus cuidados. La disbiosis, es decir, una alteración del equilibrio de la microbiota, es, de hecho, uno de los marcadores o rasgos distintivos del envejecimiento.
La disbiosis, una alteración del equilibrio de la microbiota, es uno de los marcadores o rasgos distintivos del envejecimiento
La microbiota intestinal es un factor crucial en cómo envejecemos.
¿Hay evidencia de que la modulación de la microbiota pueda retrasar el proceso de envejecimiento o prevenir enfermedades asociadas con la edad?
Sí, hay una evidencia creciente de que la modulación de la microbiota puede influir en el envejecimiento y en la prevención de enfermedades asociadas con la edad. Intervenciones como los probióticos, prebióticos y cambios en la dieta pueden alterar favorablemente la composición de la microbiota, lo que puede reducir la inflamación, mejorar la resistencia a la insulina y disminuir el riesgo de enfermedades cardiovasculares.
En concreto, ¿cuál es la importancia de la microbiota en la función cognitiva y el riesgo de deterioro cognitivo en personas mayores?
En cuanto a la función cognitiva, influye a través del eje intestino-cerebro. Un desequilibrio en la microbiota se ha asociado con enfermedades neurodegenerativas y deterioro cognitivo.
A este respecto, ¿a qué síntomas deberíamos de estar atentos?
Los síntomas a observar incluyen cambios en el estado de ánimo, memoria, concentración y comportamiento, que pueden ser indicativos de un deterioro cognitivo relacionado con la salud intestinal y la edad.
¿Existen diferencias significativas en la composición de la microbiota entre personas jóvenes y mayores?
Sí. Con la edad, la diversidad microbiana tiende a disminuir y ciertas bacterias beneficiosas pueden descender, mientras que otras, potencialmente dañinas, pueden aumentar.
¿Y entre personas que envejecen de manera saludable y aquellas con enfermedades relacionadas con la edad?
En personas que envejecen de manera saludable, la microbiota suele ser más diversa y equilibrada comparada con aquellas que tienen enfermedades relacionadas con la edad. Un envejecimiento saludable se asocia con una mayor abundancia de bacterias productoras de ácidos grasos de cadena corta, que tienen propiedades antiinflamatorias y promueven la salud intestinal. Se han realizado estudios en personas de más de 100 años con un buen estado de salud y se ha comprobado que tienen más bifidobacterias, Akkermansia muciniphila y Christensenellaceae, que las personas por ejemplo de 80 años con un mal estado de salud. Un envejecimiento no saludable se asocia a una disbiosis, es decir, un desequilibrio de la microbiota, muy parecido al que aparece en ciertas enfermedades crónicas.
Un envejecimiento saludable se asocia con una mayor abundancia de bacterias productoras de ácidos grasos de cadena corta
¿Cuál es el impacto en la microbiota de los cambios hormonales relacionados con la edad?
Los cambios hormonales, como la disminución de estrógenos en mujeres posmenopáusicas, pueden afectar a su composición. Estas transformaciones pueden llevar a una menor diversidad microbiana y a un aumento en bacterias proinflamatorias. Además, las fluctuaciones hormonales pueden influir en la permeabilidad intestinal, lo que puede aumentar la susceptibilidad a la inflamación y enfermedades crónicas. Por otro lado, la microbiota puede influir en el perfil de hormonas en la senectud.
¿Cómo afecta el estrés en la salud de la microbiota en personas mayores?
El estrés crónico puede tener un impacto negativo en la microbiota intestinal, alterando su composición y función. En personas mayores, esto puede exacerbar problemas de salud existentes y contribuir a la aparición de nuevas enfermedades. Estrategias para mitigar su impacto incluyen practicar técnicas de relajación, como meditación, yoga y ejercicios de respiración, que pueden reducir el estrés y mejorar la salud intestinal. Se debería mantener una actividad física regular. El ejercicio moderado e intenso, y sobre todo frecuente, tiene efectos positivos en la microbiota y la salud mental. También recomiendo la hormesis con baños de agua fría, saunas o baños de agua caliente. O los baños de bosque, bailar, cantar, y hacer actividades sociales y hobbies. Todo ello también reduce el estrés crónico, al igual que actividades como la pintura, la lectura o la escritura.
El ejercicio moderado e intenso, y sobre todo frecuente, tiene efectos positivos en la microbiota y la salud mental. Caminar no es suficiente
¿Qué papel juega la microbiota en la absorción de nutrientes en personas mayores?
La microbiota desempeña un papel crucial en la digestión y absorción de nutrientes. En personas mayores, puede ayudar a mejorar la absorción de vitaminas y minerales esenciales, como la vitamina B12, vitamina K, magnesio, además de los ácidos grasos esenciales y los aminoácidos.
¿Qué tipo de alimentos se deben priorizar en la dieta para mantener una microbiota saludable en la madurez?
Una alimentación prebiótica y antiinflamatoria es fundamental para la salud intestinal y el envejecimiento saludable. Los alimentos a priorizar incluyen los carbohidratos accesibles a la microbiota, sobre todo fibra soluble, como los presentes en la verdura, la fruta, las setas, los frutos secos y las legumbres. Los alimentos fermentados también son muy saludables y dan variedad a la microbiota, como yogur, kéfir, chucrut, kimchi… Además, son muy importantes los ácidos grasos omega-3 de tipo DHA y EPA presentes en el pescado y el marisco, que también contienen fosfolípidos muy interesantes para la salud cerebral, sobre todo. Por otra parte el aceite de oliva, el aguacate y los frutos secos contienen grasas saludables que modulan la microbiota de manera beneficiosa. Y es crucial asegurar una adecuada ingesta proteica, priorizando los productos del mar y también los huevos, que además contienen colina, un nutriente esencial para la salud cerebral.
¿Y hay alimentos que se deberían evitar?
Sí. Se deben evitar al máximo los ultraprocesados, repletos de azúcares refinados y edulcorantes artificiales y otros aditivos. El motivo principal es que pueden alterar negativamente la microbiota y generan inflamación crónica de bajo grado. Las grasas trans y vegetales de los productos ultraprocesados también son nefastos. Y recordemos también que el alcohol es muy perjudicial para la salud, también la de la microbiota.
¿Qué papel desempeñan los probióticos y los prebióticos en una microbiota saludable en la vejez?
Los probióticos son suplementos con cepas beneficiosas de bacterias u hongos que pueden tener beneficios para la salud de la persona que las toma. Sin embargo, si bien los alimentos fermentados contienen microorganismos vivos, no se considera que sean terapéuticos de manera específica, aunque sí mejoran la salud intestinal y global de las personas que los consumen de manera frecuente, diversa y variada.
¿Qué recomendaciones darías a las personas mayores para una buena salud intestinal?
Es clave una alimentación sin ultraprocesados, rica en verdura, setas, aceite de oliva, frutos secos, fruta, productos del mar y huevos, además de alimentos fermentados. El ayuno nocturno idealmente debería ser de 12-13 horas. Se debe evitar el picoteo entre horas, porque interrumpe un tipo de movimientos del intestino importantes para su adecuada limpieza. Por supuesto, se debe minimizar el uso excesivo de fármacos, porque no solo los antibióticos son perjudiciales para la microbiota. El ejercicio físico intenso y frecuente es otra medida clave. Pero a menudo las personas de más edad se limitan a dar algún paseo a paso muy lento, siendo esto totalmente insuficiente para cualquier persona. Caminar no es suficiente. El ejercicio de fuerza es obligatorio.
Una microbiota diversa está asociada con una menor incidencia de enfermedades crónicas y mejor función cognitiva

Una microbiota diversa está asociada con una menor incidencia de enfermedades crónicas y mejor función cognitiva.
¿Qué otros hábitos recomendarías para mantener una microbiota óptima a medida que envejecemos?
El contacto con la naturaleza, con el bosque, el mar o la montaña, también es muy beneficioso. Así como salir al aire libre todos los días y recibir la luz del sol de manera directa, sobre todo por la mañana y al atardecer. Esto, además, ayuda a regular los ritmos circadianos y mejorar el descanso nocturno. También es fundamental ir al dentista de manera periódica. Si hay una disbiosis en la boca, con bacterias como las relacionadas con la enfermedad periodontal, estas luego pasarán al intestino o incluso a la circulación sanguínea, y pueden generar muchos problemas.
¿Cómo puede la investigación sobre la microbiota ayudar a mejorar la calidad de vida de las personas mayores en el futuro?
Avances científicos recientes han revelado la importancia de la diversidad microbiana en el envejecimiento saludable. Diversos estudios han mostrado que una microbiota diversa está asociada con una menor incidencia de enfermedades crónicas y mejor función cognitiva. La investigación actual se centra en cómo su modulación mediante alimentos o patrones de dieta específicos, probióticos, prebióticos y trasplantes de microbiota fecal puede prevenir y tratar enfermedades relacionadas con la edad. En el futuro, estos avances podrían conducir a terapias personalizadas para mejorar la calidad de vida de las personas mayores.
Alimentación para una buena salud intestinal
Las 3 claves
Estas son las tres recomendaciones esenciales de la doctora Arponen para equilibrar la dieta y lograr una vejez saludable.
➡️ Consumir suficiente fibra prebiótica: es imprescindible tomar verdura y setas, y priorizar los tubérculos y otros alimentos como el boniato, la yuca, el plátano macho, frente a los cereales, que son pobres en micronutrientes y se consumen a menudo en exceso.
➡️ Hay que mantener una ingesta adecuada de agua para lograr una buena hidratación.
➡️ Es muy importante que se asegure, también, la toma de suficientes grasas saludables y proteínas, para obtener todos los aminoácidos esenciales.








